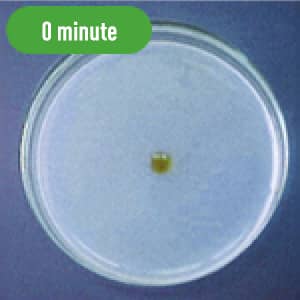
0 minute

Functional Foods Compatible Ingredients
(Japan)The Fermented Soybean Extract
“NSK-SD”
Global Sales, Extensive Reserch Data

Overview
What is Nattokinase?
It is one of the useful components produced by bacillus subtilis natto during the fermentation of soybeans, and was named “nattokinase” as an enzyme that decomposes (dissolves) fibrin, a protein of the main component of blood clots.

- (1) Thrombolytic Effect: dissolving blood clots by acting directly on the blood
- (2) Fibrinolytic Effect: activating thrombolytic substances
- (3) Anticoagulation Effect: inactivating thrombolytic inhibitors caused by stress etc.
Features
Vitamin K2
has been removed
People who take “warfarin” are normally told, by a doctor, to be restrained from eating food that contains a large amount of vitamin K2 such as natto, green/yellow vegetables and chlorella because such food weakens the effect of warfarin. To make nattokinase accessible even for these individuals, we have developed a Vitamin K2-removel technology and applied it to the production of The Fermented Soybean Extract NSK-SD.
Derived from Bacillus Subtilis Natto, Cultured in Japan
In recent years, a number of counterfeit products advocating nattokinase have been marketed. Nattokinase, produced by bacillus subtilis natto, is the name of a single enzyme whose amino acid sequence has been elucidated. However, proteolytic enzymes produced by bacteria other than bacillus subtilis natto have amino acid sequences that differ from those of nattokinase, and there are counterfeit products whose safety is questionable in terms of dietary history. We have established a simple identification method for nattokinase (IBox Test) that confirms the degradation pattern of oxidized insulin chain-β by HPLC. Using this method, nattokinase can be easily identified enzymatically. In addition, by manufacturing the product entirely in Japan, from cultivation to completion, we are able to implement thorough management and ensure high quality and safety.
Efficacy
Fibrinolytic Effect
The following pictures show the fibrinolytic effect of nattokinase (30μL (=60FU) of Fermented Soybean Extract 2,000 FU/mL) on artificial fibrin, created on a plate, over the course of time.
Blood Flow Improving Effect
The volume of blood flow increased with the intake of NSK-SD and, thus, the blood flow improving effect was observed.

Blood Pressure Reducing Effect
The reduction in systolic blood pressure and diastolic blood pressure after the intake of NSK-SD was observed.

- Peripheral Body Temperature Maintenance Effect
- Antiviral Effect
- Immunostimulatory Effect (Activation on Natural Killer Cells)
- Inhibitory Effect on AGEs (Advanced Glycation End Products) formation
Safety
Safety Tests
- 1Single Oral Dose Toxicity Study
- 213-week Repeated Oral Dose Toxicity Study
- 3Chromosomal Aberration Test
- 4Ames Test
- 5Pathogenicity Study of NSK-SD Producing Bacteria
- 6Safety Study on Taking Natural Super Kinase-II
- 7Safety Study on Concomitant Use of Warfarin and Nattokinase
Safety Management
※The safety mentioned here only applies to our product, NSK-SD. Therefore this does not apply to nattokinase materials of other manufacturers.
Specifications
Fermented Soybean Extract
NSK-SD
- Property
- fine powder, white to milky white in colour with a slight natto odour
- Specification
-
Nattokinase Activity: More than 20,000 FU/g
Vitamin K2: Less than 0.1 ppm

Recommended Intake
-
Japan Health and Nutrition Food Association (JHFA) Standard
JHFA has set criteria for the recommended daily intake of “fermented soybean extract food” as follows.
Japan Health and Nutrition Food AssociationFermented soybean extract processed food… More than 2,000 FU as nattokinaseFermented soybean extract containing food… More than 1,000 FU, under 2,000 FU as nattokinase -
Japan NattoKinase Association (JNKA) Standard
The products which meet the following four criteria are considered to meet JNKA’s standard and, thus, are allowed to put the JNKA mark.
Japan NattoKinase Association (JNKA) Standard- 1.Contain Bacillus subtilis natto products
- 2.Contain More than 2,000 FU/day of nattokinase
- 3.Indicate the nattokinase content with FU
- 4.The safety is proved
We have suggested and enlightened a nattokinase activity measuring method (fibrin degrading method) using fibrin as a substrate. It has been applied to the standard judgement of JHFA and JNKA and “FU” has become well-known as the unit that indicates nattokinase activity.